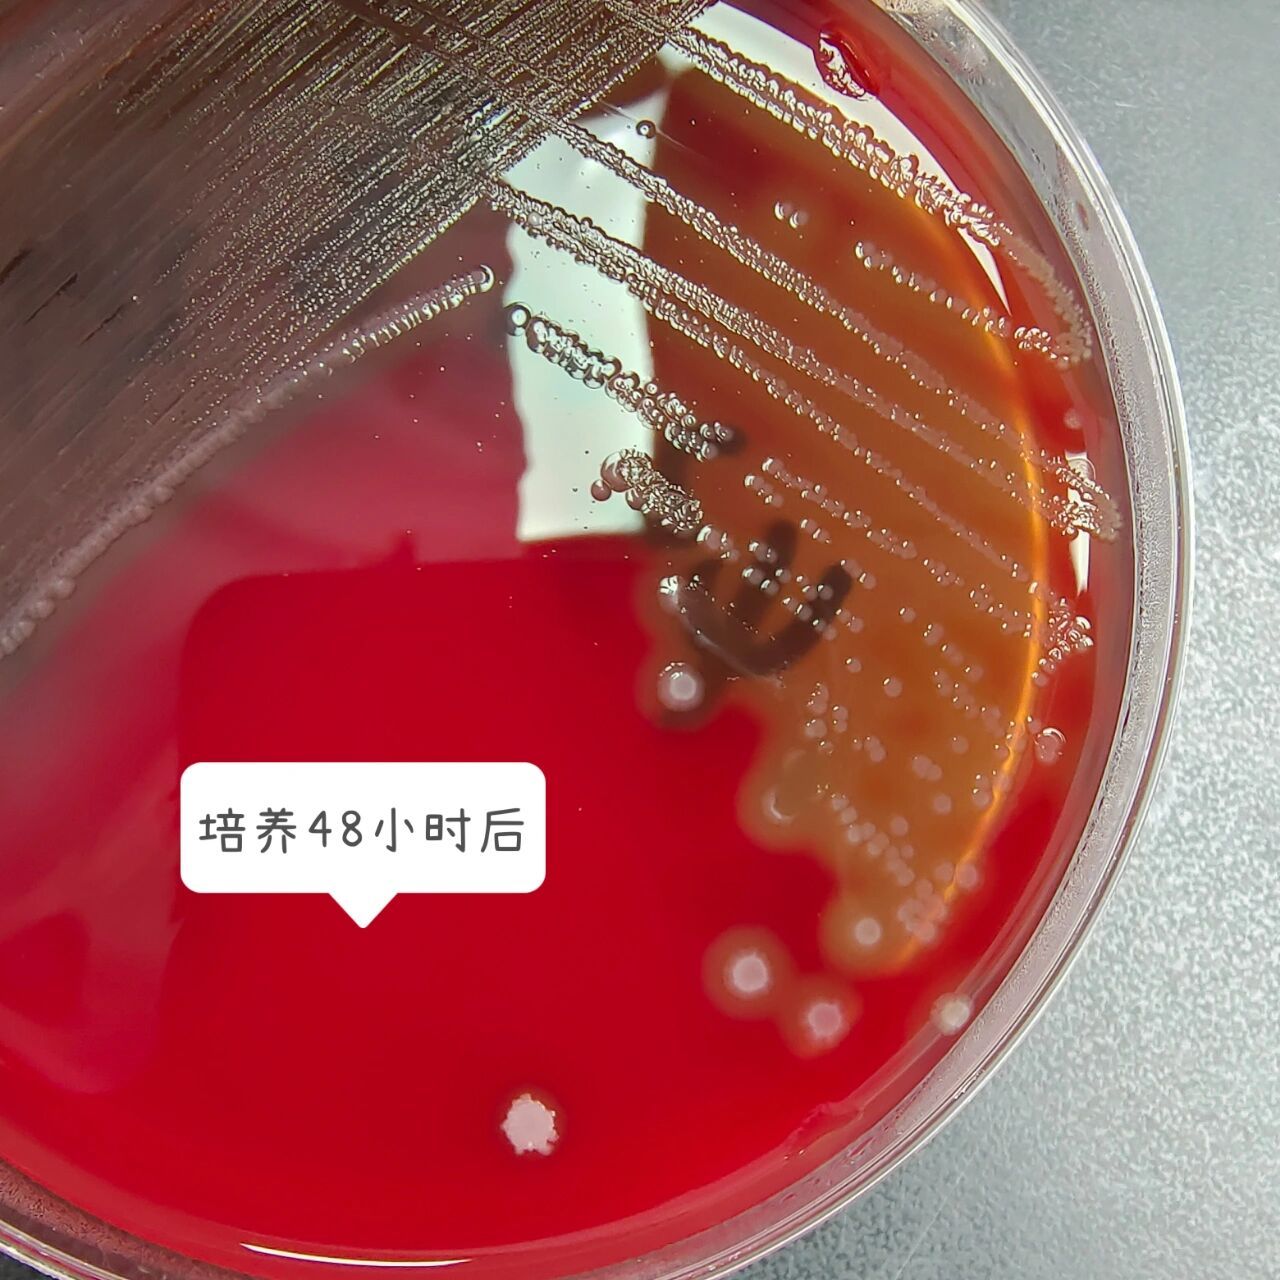
化脓性链球菌 革兰阳性球菌,单个,成双或链状排列,菌落较小,有β溶血
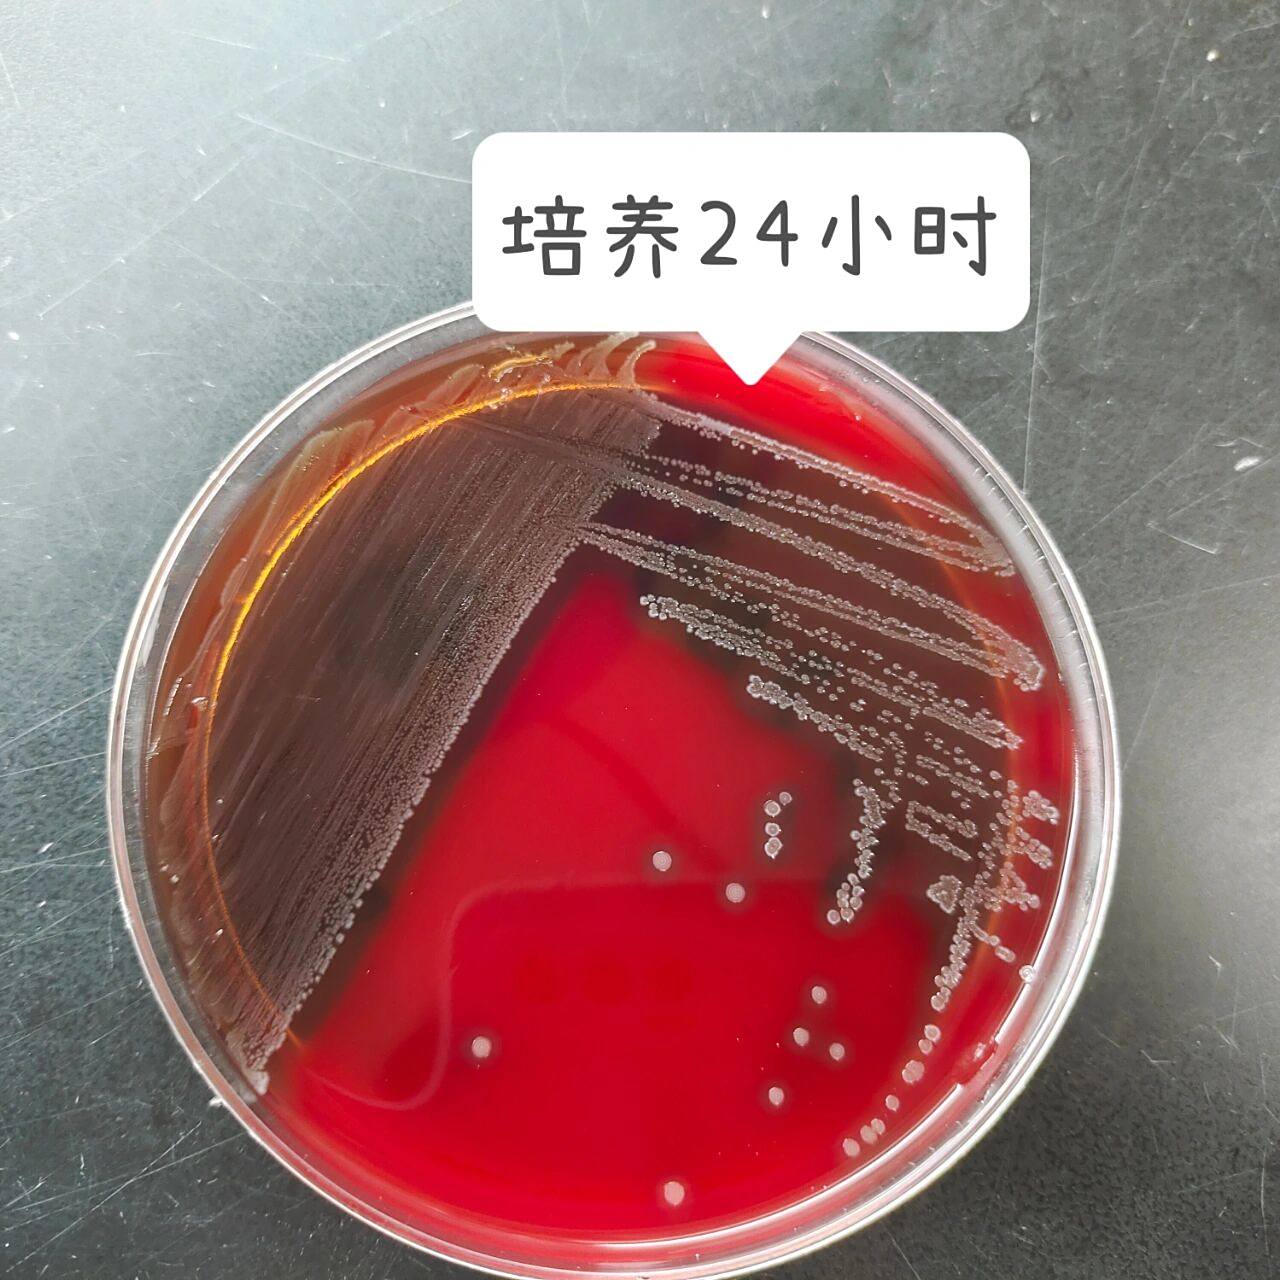
化脓性链球菌 革兰阳性球菌,单个,成双或链状排列,菌落较小,有β溶血
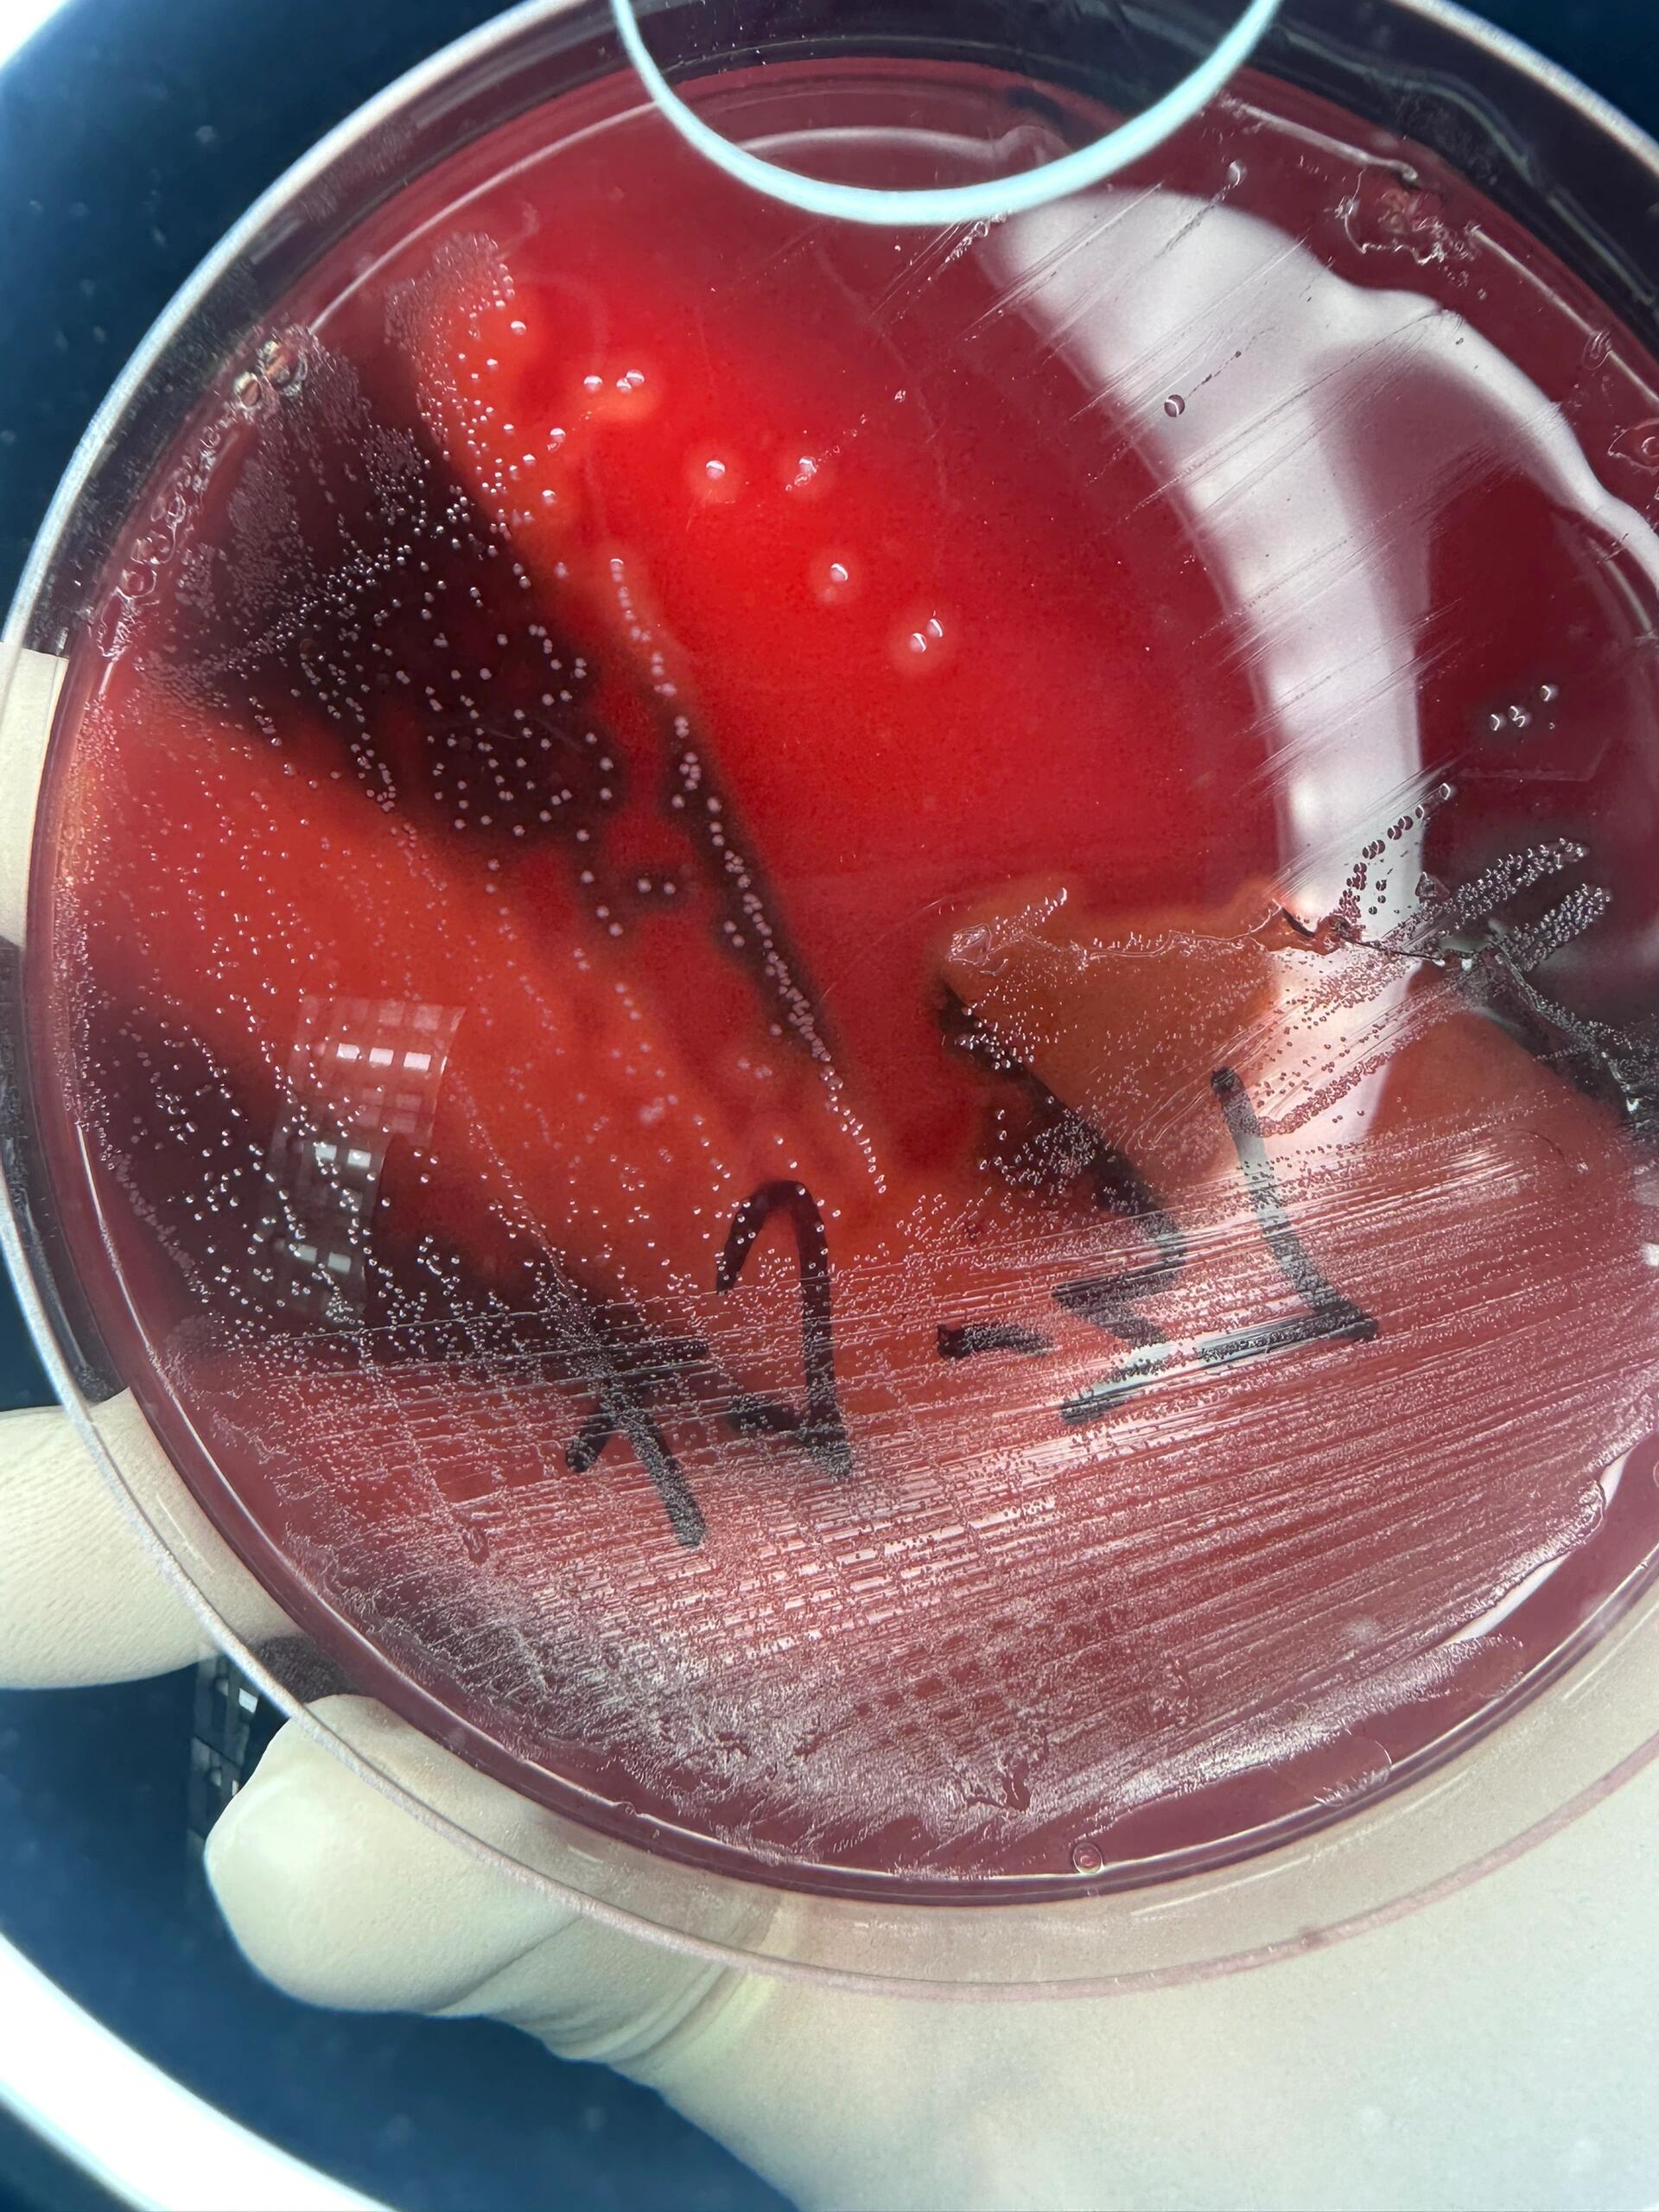
a族链球菌 化脓性链球菌 菌落形态 这两株菌都是化脓链球菌,培养时间
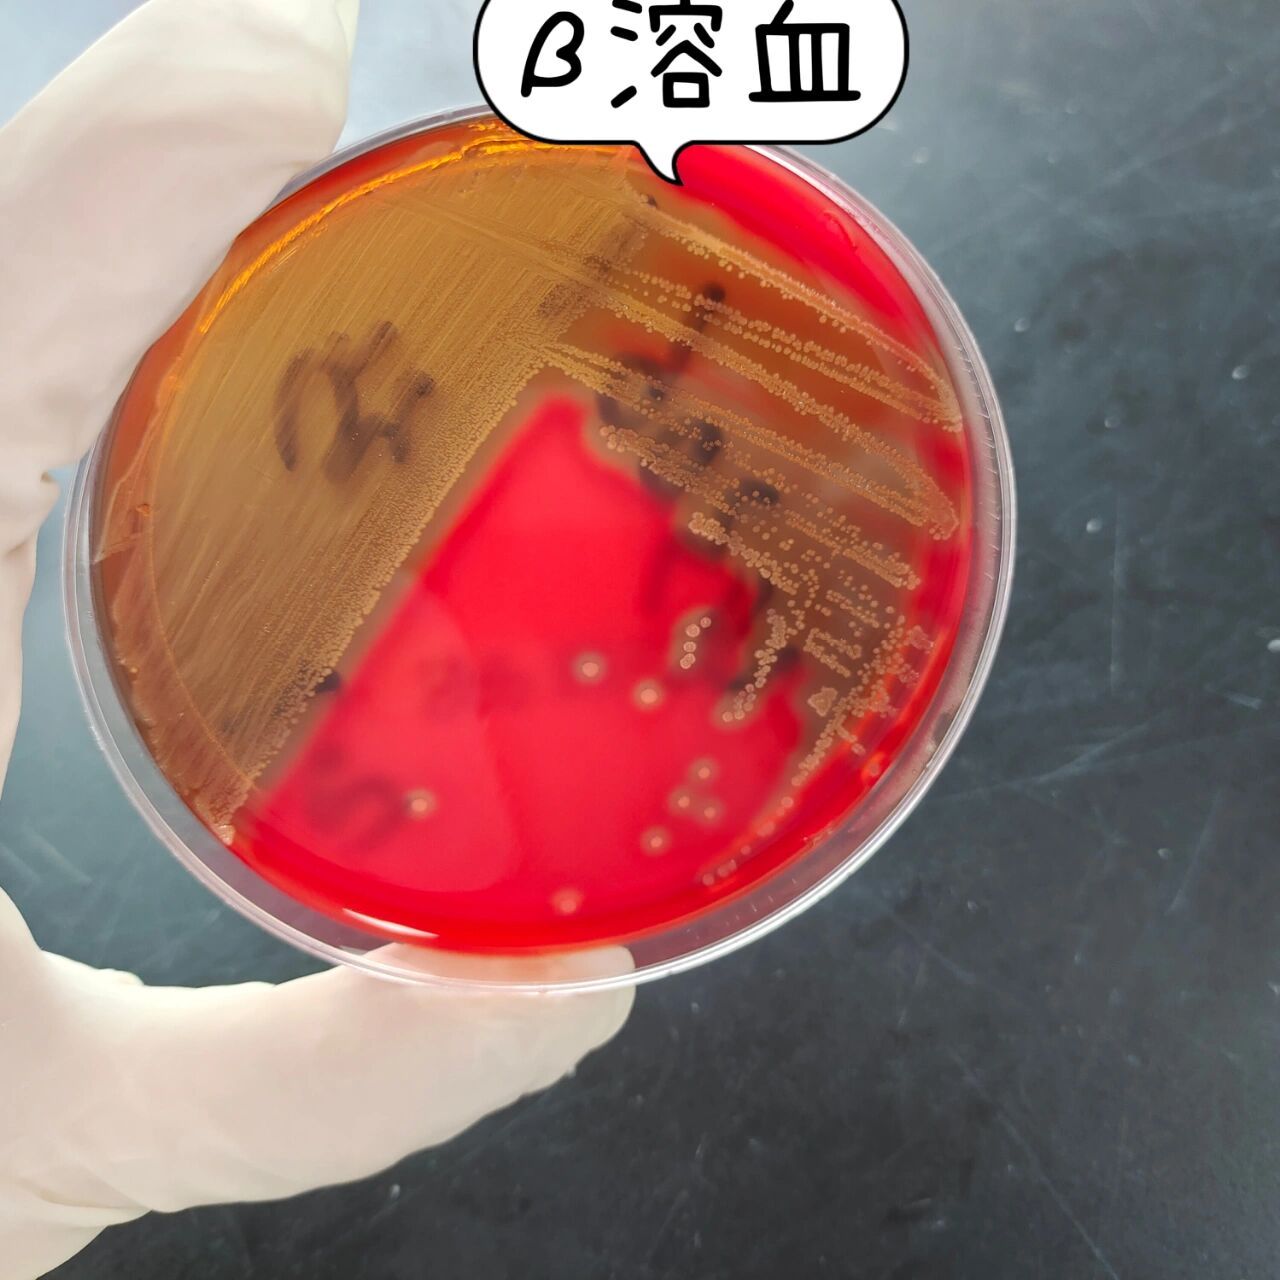
化脓性链球菌 革兰阳性球菌,单个,成双或链状排列,菌落较小,有β溶血

化脓性链球菌菌落

链球菌菌落对血ag具有溶血性图片下载
图片尺寸800x533
化脓性链球菌 革兰阳性球菌,单个,成双或链状排列,菌落较小,有β溶血
图片尺寸1280x1280
化脓性链球菌 革兰阳性球菌,单个,成双或链状排列,菌落较小,有β溶血
图片尺寸1280x1280
a族链球菌 化脓性链球菌 菌落形态 这两株菌都是化脓链球菌,培养时间
图片尺寸1920x2560
化脓性链球菌 革兰阳性球菌,单个,成双或链状排列,菌落较小,有β溶血
图片尺寸1280x1280
左下肢化脓性链球菌感染
图片尺寸2976x2976
化脓链球菌
图片尺寸328x194
左下肢化脓性链球菌感染
图片尺寸2976x2976
pyogenes 化脓性链球菌引起,是一种严重的皮肤(有时是肌肉)感染,通过
图片尺寸350x510
左下肢化脓性链球菌感染
图片尺寸2976x2976
streptococcuspyogenes化脓性链球菌
图片尺寸1080x1440
左下肢化脓性链球菌感染
图片尺寸2976x2976
肺炎链球菌产生自溶酶,会出现脐窝状菌落.
图片尺寸660x772
图-4 链球菌在脑心琼脂固体培养基平板(bhia)上形成的菌落特征表-3
图片尺寸632x632
每天分享一种细菌呦~化脓链球菌定植于人的咽及皮肤等部位,具有复杂
图片尺寸1080x1438
肺炎链球菌菌落
图片尺寸3264x2448
化脓链球菌
图片尺寸1920x2560
化脓性链球菌 (其他生物相关)
图片尺寸1200x900
革兰阳性双球菌,α-溶血性链球菌,菌落细小扁平或呈脐窝状.
图片尺寸1080x1080
化脓性链球菌复发感染如何影响大脑功能
图片尺寸400x245